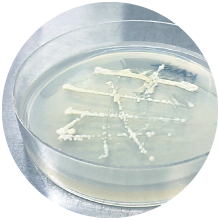
群馬KAZE酵母

本文
群馬県の地酒「舞風」
オール群馬県産日本酒 舞風
群馬県酒造組合、群馬県農業技術センター、群馬県立産業技術センターの協力により開発したオール群馬の地酒「舞風」。
群馬が生んだ酒造好適米「舞風」、「群馬KAZE酵母」などの群馬県開発の清酒酵母、そして、「群馬の水」で醸した「群馬生まれ、群馬育ち」の地酒です。

群馬県産 酒造好適米「舞風」
「群馬KAZE酵母」などの群馬県産清酒酵母

群馬県の「仕込み水」
群馬だからこそできる酒。
せっかくここに生まれ、育てられたのだから― その思いを酒造りに込めています。
それぞれの地域の味を醸し出す、新しい風を吹かせる酒です。
MESSAGE
大利根酒造 阿部倫典氏に聞く ぐんまの地酒「舞風」の魅力
MAIKAZE
※掲載品は29BY(平成29年度)版です。最新の情報は各社へ直接お問い合わせください。
|
町田酒造店 |
柳沢酒造 |
聖酒造 |
牧野酒造 |
柴崎酒造 |
|
高井 |
松屋酒造 |
聖徳銘醸 |
貴娘酒造 |
大利根酒造 |
|
永井酒造 |
近藤酒造 |
分福酒造 |
山川酒造 |
島岡酒造 |
清嘹 舞風
| 清嘹 舞風 | |
|---|---|
![]() |
特別本醸造 原材料:米、米麹、醸造アルコール キレイでまろやかな酒。 町田酒造店(前橋市)<外部リンク> |
純米大吟醸 舞風 桂川
| 純米大吟醸 舞風 桂川 | |
|---|---|
![]() |
純米大吟醸 原材料:米、米麹|精米歩合:50% 香り高く、キレのある酸味が特徴。食中酒に向きます。 柳沢酒造 |
かんとうのはな
| かんとうのはな | |
|---|---|
![]() |
純米吟醸 原材料:米、米麹|精米歩合:60% ここちよい酸味とまろやかな米の旨み。 聖酒造<外部リンク> |
榛名山
| 榛名山 | |
|---|---|
![]() |
純米大吟醸 原材料:米、米麹|精米歩合:50% 舞風、群馬酵母、榛名山伏流水を用いて、丁寧に醸し上げた逸品です。 牧野酒造<外部リンク> |
船尾瀧
| 船尾瀧 | |
|---|---|
![]() |
特別純米酒 原材料:米、米麹|精米歩合:55% ドライな口あたり、シャープなキレ。 柴崎酒造<外部リンク> |
巌 純米吟醸 舞風
| 巌 純米吟醸 舞風 | |
|---|---|
![]() |
純米吟醸 原材料:米、米麹|精米歩合:55% 全体的にきれいな骨格に、果実様の香りが彩る。 高井 |
平井城
| 平井城 純米吟醸 舞風 | |
|---|---|
![]() |
純米吟醸 原材料:米、米麹|精米歩合:60% 舞風米を使用した、香りのある辛口。 松屋酒造<外部リンク> |
舞風 純米吟醸原酒
| 舞風 純米吟醸原酒 | |
|---|---|
![]() |
純米吟醸 原材料:米、米麹|精米歩合:麹米60%・掛米60% 原酒ならではの強い味わいとほのかな吟醸香が特徴。 聖徳銘醸 |
風の詩
| 風の詩 | |
|---|---|
![]() |
純米大吟醸 原材料:米、米麹|精米歩合:50% 純米大吟醸ならではのフルーティな香りと米の旨みが特徴。 貴娘酒造 |
舞
| 舞 | |
|---|---|
![]() |
純米吟醸 原材料:米(国産)、米麹(国産米) ふくよかな香りと透き通るような爽やかさ、芳醇な味わい。 大利根酒造<外部リンク> |
谷川岳 舞風 純米吟醸
| 谷川岳 舞風 純米吟醸 | |
|---|---|
![]() |
純米吟醸 原材料:米、米麹|精米歩合:60% スッキリとしたキレイな味が特徴。 永井酒造<外部リンク> |
赤城山
| 赤城山 | |
|---|---|
![]() |
純米吟醸 原材料:米、米麹|精米歩合:50% 地元みどり市産米舞風で造った、旨口で飲み口さっぱりとした、お酒です。 近藤酒造<外部リンク> |
分福
| 分福 舞風 純米吟醸 | |
|---|---|
![]() |
純米吟醸 原材料:米(国産)、米麹(国産米)|精米歩合:55% 地元館林産舞風を原料にじっくりと醸された香り華やか、旨みとキレのある辛口純米吟醸酒です。 分福酒造<外部リンク> |
利根川育ち
| 利根川育ち | |
|---|---|
![]() |
純米酒 原材料:米、米麹|精米歩合:60% 米の旨みと天然の乳酸菌に由来する酸味の調和。 山川酒造 |
群馬泉 舞風
| 群馬泉 舞風 | |
|---|---|
![]() |
純米酒 原材料:米、米麹|精米歩合:60% 若々しい酸味とスッキリした透明感のある味わいのお酒。 島岡酒造<外部リンク> |
※掲載品は29BY(平成29年度)版です
「舞風シンボルマーク」について

「オール群馬の地酒」が平成24年4月にデビューにともない一般公募でデザインを募集した作品409点の中から選ばれました。
作者コメント
「風が舞い稲穂が舞い人が舞うをイメージに群馬の頭文字Gをモチーフにオール群馬産をアピールするシンボルマークです。
原料のこだわりを強調するため文字を融合したデザインです。
舞風100%のオール群馬産シンボルとして末永く親しまれるマークです。」






























